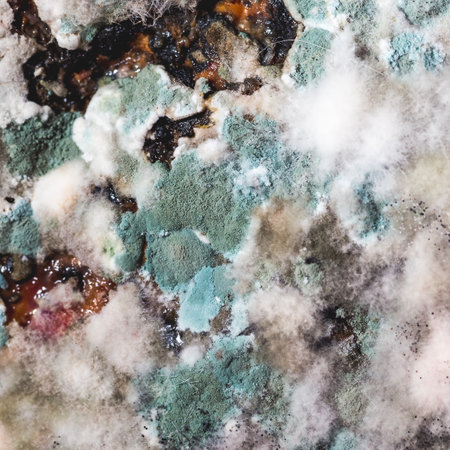
Pumpkin covered with mold and fungus. Texture background for designers.の写真素材

写真素材 - Pumpkin covered with mold and fungus. Texture background for designers.
作品情報
Pumpkin covered with mold and fungus. Texture background for designers.
- ID:160276751
- 作品種別:写真
- 作者名:bearok
キーワード
- 1 1 aspect ratio
- allergy
- awful
- backdrop
- background
- bacteria
- biology
- closeup
- dirty
- disease
- expired
- food
- fungal
- fungi
- fungus
- gourd
- harmful
- inedible
- infected
- infection
- microbe
- mildew
- mold
- moldy
- mouldy
- musty
- natural
- nature
- old
- orange
- organic
- penicillin
- plant
- pumpkin
- putrid
- raw
- rot
- rotten
- scary
- spoiled
- spore
- spores
- spread
- square
- square format
- squash
- texture
- unhealthy
類似作品
Close-up of a s...
Close-up of a s...
covered with mo...
Black mold on t...
Spoiled pumpkin...
Close-up of mol...
Close-up of a s...
Various Rotten ...
Spoiled pumpkin...
Macro, pumpkin ...
Orange moldy cu...
big pumpkin wit...
Rotten pumpkin ...
Old electricity...
Two rotten pump...
Orange moldy cu...
mold on the rot...
Top view of a r...
A close-up of a...
spoiled food ro...
a bag full of r...
Vile mold
Moldy pumpkin o...
Mould growing o...
Very Close Mac...
macro, pumpkin ...
Rotten pumpkin ...
Closeup photogr...
Mold macro. Mol...
A rotten pumpki...
Orange moldy cu...
fungal mildew o...
rotten pumpkin ...
Rotten spoiled ...
moldy and stain...
Rotten spoiled ...
Fossil coral tr...
hands wearing r...
Large grey mold...
macro, pumpkin ...
black mold roun...
Rotten moldy go...
Pumpkin that st...
Moldy spoiled p...
Pumpkin ugly wi...
With a pebbly t...
Spoiled turnip
covered with mo...
Mold on an oran...